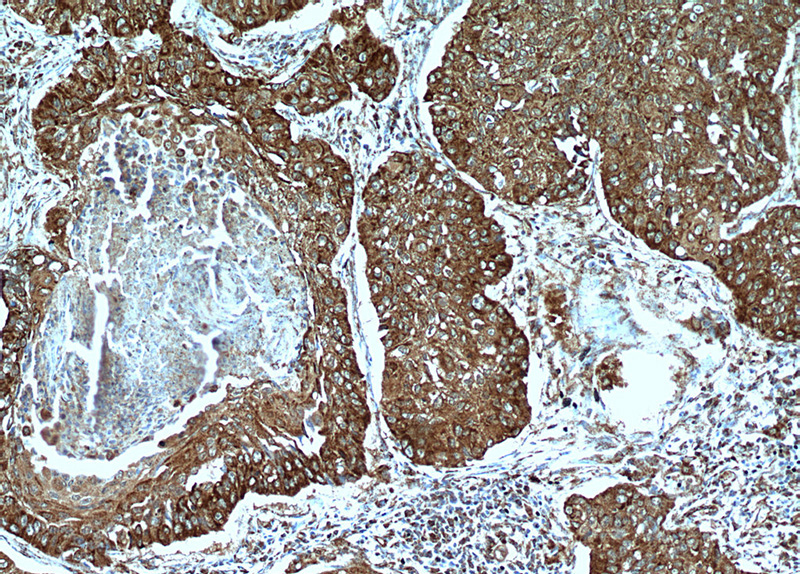
Immunohistochemical of paraffin-embedded human lung cancer using Catalog No:115731(STOML2 antibody) at dilution of 1:100 (under 10x lens)
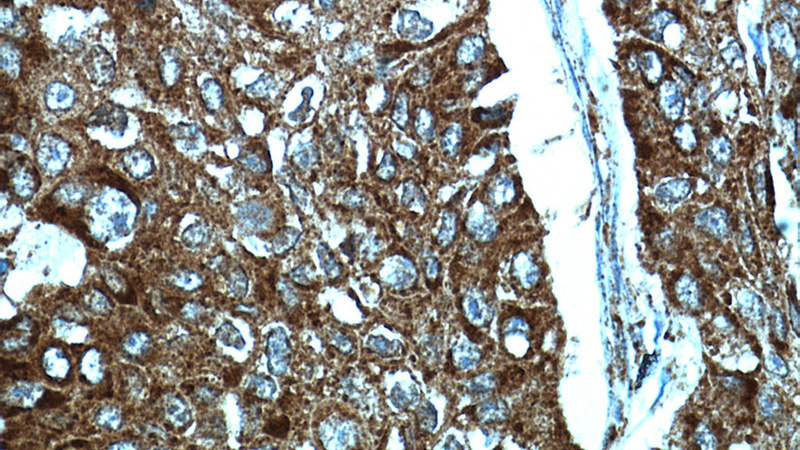
Immunohistochemical of paraffin-embedded human lung cancer using Catalog No:115731(STOML2 antibody) at dilution of 1:100 (under 40x lens)

-
Product Name
STOML2 antibody
- Documents
-
Description
STOML2 Rabbit Polyclonal antibody. Positive IF detected in MCF-7 cells. Positive IHC detected in human lung cancer tissue, human breast cancer tissue, human endometrial cancer tissue. Positive WB detected in C6 cells, mouse brain tissue. Positive IP detected in mouse brain tissue. Observed molecular weight by Western-blot: 39 kDa
-
Tested applications
ELISA, IF, IP, WB, IHC
-
Species reactivity
Human,Mouse,Rat; other species not tested.
-
Alternative names
EPB72 like protein 2 antibody; HSPC108 antibody; SLP 2 antibody; SLP2 antibody; stomatin (EPB72) like 2 antibody; Stomatin like protein 2 antibody; STOML2 antibody
- Immunogen
-
Isotype
Rabbit IgG
-
Preparation
This antibody was obtained by immunization of STOML2 recombinant protein (Accession Number: NM_013442). Purification method: Antigen affinity purified.
-
Clonality
Polyclonal
-
Formulation
PBS with 0.1% sodium azide and 50% glycerol pH 7.3.
-
Storage instructions
Store at -20℃. DO NOT ALIQUOT
-
Applications
Recommended Dilution:
WB: 1:500-1:5000
IP: 1:500-1:5000
IHC: 1:20-1:200
IF: 1:20-1:200
-
Validations
Immunohistochemical of paraffin-embedded human lung cancer using Catalog No:115731(STOML2 antibody) at dilution of 1:100 (under 10x lens)
Immunohistochemical of paraffin-embedded human lung cancer using Catalog No:115731(STOML2 antibody) at dilution of 1:100 (under 40x lens)

Immunofluorescent analysis of MCF-7 cells, using STOML2 antibody Catalog No:115731 at 1:50 dilution and Rhodamine-labeled goat anti-rabbit IgG (red). Blue pseudocolor = DAPI (fluorescent DNA dye).

IP Result of anti-STOML2 (IP:Catalog No:115731, 3ug; Detection:Catalog No:115731 1:1000) with mouse brain tissue lysate 1000ug.

C6 cells were subjected to SDS PAGE followed by western blot with Catalog No:115731(STOML2 Antibody) at dilution of 1:1000
-
Background
STOML2 (Stomatin-like protein 2; also known as SLP-2) is a widely expressed mitochondrial member of the highly conserved family of stomatin proteins. STOML2 is localized mostly in mitochondrial inner membrane, minor in plasma membrane. Human STOML2 interacts with prohibitins and regulates mitochondrial biogenesis and function (21746876). In addition, plenty of studies revealed that STOML2 was overexpressed in many human cancer tissues, and its expression may be a new valuable prognostic biomarker (19839737, 21960069). Recently STOML2 has been identified as a serological biomarker for early colorectal cancer (CRC) diagnosis (21209152).
-
References
- Kirchhof MG, Chau LA, Lemke CD. Modulation of T cell activation by stomatin-like protein 2. Journal of immunology (Baltimore, Md. : 1950). 181(3):1927-36. 2008.
- Mitsopoulos P, Chang YH, Wai T. Stomatin-like protein 2 is required for in vivo mitochondrial respiratory chain supercomplex formation and optimal cell function. Molecular and cellular biology. 35(10):1838-47. 2015.
- Richter-Dennerlein R, Korwitz A, Haag M. DNAJC19, a mitochondrial cochaperone associated with cardiomyopathy, forms a complex with prohibitins to regulate cardiolipin remodeling. Cell metabolism. 20(1):158-71. 2014.
- Sun F, Ding W, He JH, Wang XJ, Ma ZB, Li YF. Stomatin-like protein 2 is overexpressed in epithelial ovarian cancer and predicts poor patient survival. BMC cancer. 15:746. 2015.
- Bartolome A, Boskovic S, Paunovic I, Bozic V, Cvejic D. Stomatin-like protein 2 overexpression in papillary thyroid carcinoma is significantly associated with high-risk clinicopathological parameters and BRAFV600E mutation. APMIS : acta pathologica, microbiologica, et immunologica Scandinavica. 2016.
- Zhang L, Ding F, Cao W. Stomatin-like protein 2 is overexpressed in cancer and involved in regulating cell growth and cell adhesion in human esophageal squamous cell carcinoma. Clinical cancer research : an official journal of the American Association for Cancer Research. 12(5):1639-46. 2006.
- Chang D, Ma K, Gong M. SLP-2 overexpression is associated with tumour distant metastasis and poor prognosis in pulmonary squamous cell carcinoma. Biomarkers : biochemical indicators of exposure, response, and susceptibility to chemicals. 15(2):104-10. 2010.
- McCray BA, Skordalakes E, Taylor JP. Disease mutations in Rab7 result in unregulated nucleotide exchange and inappropriate activation. Human molecular genetics. 19(6):1033-47. 2010.
Related Products / Services
Please note: All products are "FOR RESEARCH USE ONLY AND ARE NOT INTENDED FOR DIAGNOSTIC OR THERAPEUTIC USE"
